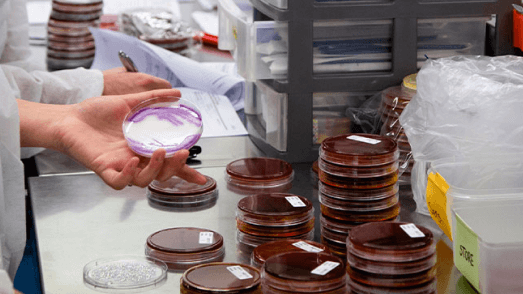
Advanced diagnostics and disease surveillance

Cart Summary
Promoting Pig health,
welfare & production
Our ProSwine team is passionate about the Australian pork industry. We are committed to providing our clients with the highest standard of veterinary service, diagnostics and technology.

Holistic animal health services
ProSwine is a comprehensive veterinary consultancy service providing production advice and data analysis to the Australian pig industry.
Our ProSwine team is comprised of industry-leading pig consultant veterinarians providing veterinary advice and products to commercial piggeries in Queensland, New South Wales, Victoria, South Australia and Western Australia. We work with our clients in all aspects of their business from strategic planning and analytical services to disease investigation and surveillance. Our focus on preventative health and antimicrobial stewardship through customised animal health treatment protocols and staff training helps our clients to produce safe and sustainable Australian pork.
Learn more
Advanced diagnostics and disease surveillance
ProSwine captures advanced diagnostics and customised preventative vaccines through ACE Laboratory Services.
The ProSwine team actively collaborates with ACE Laboratory Services in the development of farm-specific vaccines. This partnership strengthens our ability to provide customised preventative health care that meets the needs of our clients and their animals. ACE Laboratory Services also delivers leading diagnostic testing for disease investigation purposes and on-going surveillance. Antimicrobial resistance testing and reporting allows our ProSwine vets to maintain judicious use of antimicrobials at the individual and herd level.
Learn more

Industry-leading innovation and technology
ProSwine invests in the future sustainability of the Australian pig industry through the development of new products and technologies.
Research and Development is integral to the success of ProSwine. Our aim is to deliver proven products and technologies to our clients, enabling them to operate more efficiently with improved animal wellbeing. ProSwine clients have the ability to order approved restricted products on-line as well as having access to consultancy reports, plans and diagnostics results.
Learn more

Personalised online shop

Animal health protocols

Quick-access reports and results





